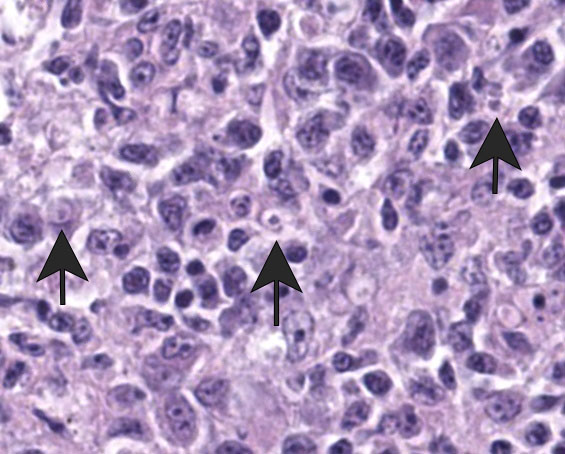
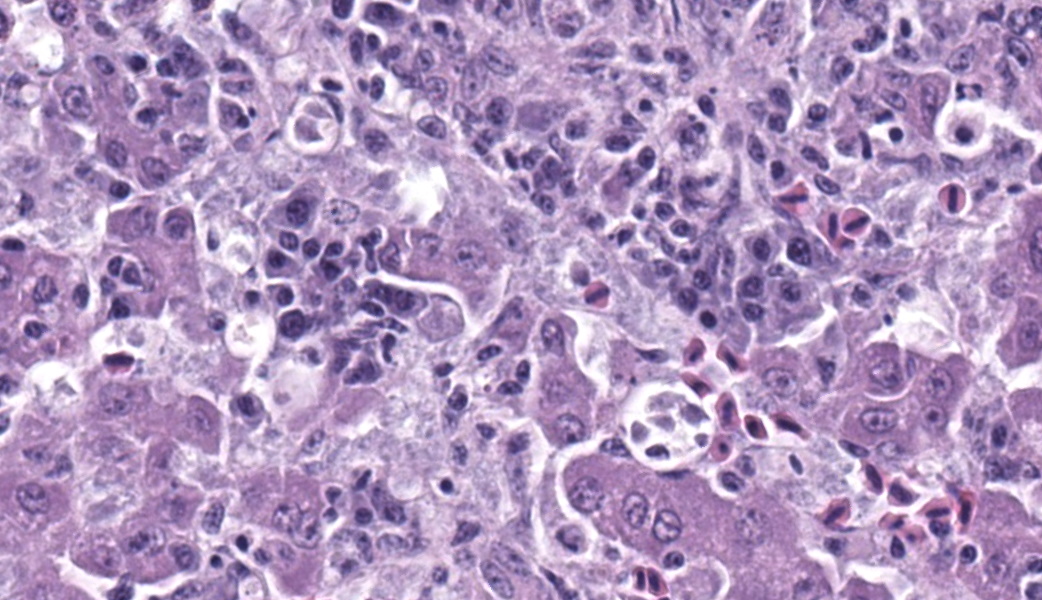

Conference 20, Case 3
Signalment:
5-month-old, female black-winged starling (Acridotheres melanopterus)
History:
This was a parent-raised bird hatched in a mixed species aviary. It was found dead in the habitat with no previous clinical history.
Gross Pathology:
Postmortem and body condition were good with mild autolysis and moderate fat stores. The liver was enlarged filling much of the coelomic cavity and mottled shades of tan and brown. The spleen was enlarged at 3 x 0.5 x 0.5 cm. The upper gastrointestinal tract was empty and the small and large intestinal loops were diffusely mildly dilated.
Laboratory Results:
In-house cPCR assays with sequencing (frozen lung and duodenum):
- Isospora-specific cytochrome c oxidase: Isospora serini (BLAST Accession ON584773), 96.7-96.9% identical
- Trichomonas 18S rRNA: Cochlosoma anatis (BLAST Accession AY247745), 92.7% identical
Electron microscopy, California Animal Health and Food Safety Lab in Davis, CA (formalin-fixed liver):
- Free organisms- family Trichomonadidae flagellates with 5 apical flagella (one recurrent)
- Lymphocytes- Intracytoplasmic Isospora
Microscopic Description:
Liver: Surrounding portal regions and occasionally coalescing are infiltrates of moderate numbers of lymphocytes and histiocytes that disrupt the hepatic architecture. Within the lymphocytes and histiocytes are numerous, 2 um in diameter, basophilic protozoal organisms surrounded by a thin, clear halo that peripheralizes the nucleus. The inflammatory cells separate and individualize the hepatocytes, which display mild karyomegaly and frequent binucleation. Free within the sinusoidal lumina and within portal and central veins are numerous, approximately 5 um diameter, pyriform flagellate protozoa with a single, variably distinct nucleus. Occasional large lymphocytes and rare plasma cells circulate throughout the sinusoids.
Duodenum: The mucosal lamina propria is markedly infiltrated and expanded by numerous lymphocytes and histiocytes with rare plasma cells. The inflammatory cells broaden and occasionally fuse the villi and separate the intestinal crypts. Within the mononuclear cells are abundant 2 um diameter, basophilic protozoal organisms surrounded by a thin, clear halo that peripheralizes and indents the nucleus. The crypt epithelial cells are often pyknotic and sloughed into the lumen. Epithelial cells at the crypt bases are often hyperplastic, piling three to four cells thick with increased numbers of mitotic figures. The coelomic fat surrounding the duodenum has small, multifocal aggregates of lymphocytes.
Cloaca, colon, and bursa of Fabricius: The lamina propria of the colon is infiltrated and expanded by moderate numbers of lymphocytes and plasma cells that separate colonic crypts. Multifocal crypts are filled with numerous, approximately 5 um diameter, pyriform flagellates with a single, variably distinct nucleus. Similar flagellates are also identified in large numbers within the lumen. Within the bursa of Fabricius, there are similar trichomonad flagellates as well as approximately 2-3 um diameter, round, protozoal organisms that are often adhered to the superficial surface of the epithelial cells.
Contributor's Morphologic Diagnosis:
Liver: Moderate, multifocal, chronic, lymphohistiocytic hepatitis with intracellular protozoa (consistent with isosporosis, Isospora sp) and sinusoidal flagellates
Duodenum: severe, chronic, segmental, histiocytic enteritis, with abundant intracellular protozoa (consistent with isosporosis, Isospora sp.)
Cloaca and bursa of Fabricius: moderate, chronic, proliferative and lymphoplasmacytic cloacitis and bursitis with superficial mucosal protozoa, consistent with cryptosporidiosis, Cryptosporidium sp.
Colon and cloaca: myriad crypt and luminal flagellates
Contributor's Comment:
This young black-winged starling had two clinically significant systemic protozoal infections, confirmed by PCR assays and electron microscopy, that likely led to its death. A third suspected protozoal infection was seen histologically in the cloaca and bursa of Fabricius but not confirmed with ancillary testing. Gizzard candidiasis completed the picture of a bird with an immature or deficient immune system despite its apparently adequate nutritional status.
Systemic isosporosis was identified histologically and cytologically in histiocytes and lymphocytes of an inflammatory response affecting small intestine, liver, spleen, and other tissues. Isosporosis is well-described in captive and free-range passerines. Formerly known as atoxoplasmosis, the pathogenesis of systemic isosporosis remains uncertain but involves extraintestinal invasion of mononuclear cells by sporozoites that undergo asexual reproduction. It is endemic in populations of passerines with fatal infections associated with stress, concurrent infections, or immunosuppression.3 Mortality due to Isosporasp in wild birds is low, however, mortality in captive birds is significantly higher. Stress due to captivity and increased shedding of infective oocysts have been proposed as possible causes for the higher mortality observed in captive passerines.3 As seen in this case, isosporosis is most commonly seen in the proximal segments of the small intestine and is accompanied by infiltration by mononuclear cells. Compromise to the intestinal mucosa as a result of the severe inflammation in this case could have led to invasion by the second protozoal infection.
Present in often very large numbers throughout the vasculature were extracellular protozoa consistent with flagellates that could have contributed to the inflammation in some tissues. Using a trichomonad PCR assay, sequences with a closest match to Cochlosoma anatis were obtained from both lung and intestine, although identity was only ~93%. Electron microscopy of liver tissue confirmed intracellular protozoa consistent with Isospora, and extracellular flagellates consistent with tetratrichomonads based on the presence of 5 undulipodia at the apical pole with one recurrent. In contrast, Cochlosoma sp. have six flagella, one of which is recurrent. Both Cochlosoma and Trichomonas have a single nucleus, a parabasal apparatus, a tubular axostyle, and a crescent-shaped pelta.6 Prior studies have identified via sequence analysis of the 16S rRNA gene that Cochlosoma and Trichomonas are genetically similar, which likely accounts for the 93% identity match.4Tetratrichomonas and C. anatis are often identified with other intestinal pathogens and their pathogenicity as a sole pathogen remains uncertain.1,4 Both have been documented as the cause of fulminant disease in a variety of birds. Tetratrichomoniasishas been identified as the causative agent of acute typhlohepatitis in ducks, a necrotizing hepatitis and splenitis in a Waldrapp ibis and necrotizing hepatitis in a free-ranging white pelican.1,2Cochlosoma anatis is linked to enteritis in turkeys, as well as increased dehydration, malabsorption, and mortality in young finches.4 However, prior studies have failed to document clinical signs or histologic lesions in experimental infections with Trichomonas and coinfections of Cochlosoma with other intestinal pathogens have demonstrated greater pathogenicity than with either pathogen alone.1,4
Flagellates were also present in the colonic and cloacal lumen, including deep in the crypts. In this location, their visualization was complicated by suspected cryptosporidiosis, the third protozoal infection, which was best seen in the bursa of Fabricius. The cryptosporidiosis within the bursa of Fabricius was not confirmed via ancillary diagnostics, but the appearance in this location was typical, though less common than proventricular cryptosporidiosis in passerines. The colonization of the bursa by the Cryptosporidium and the resulting bursitis may have impaired the humoral immune response, further predisposing the starling to the multiple concurrent protozoal infections.
Contributing Institution:
Disease Investigations
San Diego Zoo Wildlife Alliance
PO Box 120551
San Diego, CA 92112
https://science.sandiegozoo.org/disease-investigations
JPC Morphologic Diagnosis:
1. Liver: Cholangiohepatitis, histiocytic and lymphoplasmacytic, chronic, diffuse, marked, with intrahistiocytic apicomplexan zoites and sinusoidal flagellates.
2. Duodenum: Enteritis, histiocytic, chronic, diffuse, severe, with intrahistiocytic apicomplexan zoites.
3. Cloaca: Cloacitis, proliferative and histiocytic, chronic, diffuse, marked, with numerous luminal flagellates.
4. Bursa of Fabricius: Bursitis, necrotizing, chronic, multifocal, mild, with intraluminal flagellates.
JPC Comment:
Many thanks to this contributor for an interesting case and well-written comment! It has been a while since the WSC saw a case of atoxoplasmosis (WSC 2009, Conf 18, Case 3), and this case provided some excellent discussion points. This was a challenging slide for many participants due to the lymphoproliferative nature of this protozoal infection, which, depending on the severity of the infection and the species affected, can be confused with lymphoma caused by gallid herpesvirus-2 (Marek?s disease), and avian retrovirus (lymphoid leukosis), etc.3 This was true in this conference, and some participants wondered about a lymphoma as the primary disease with the protozoa being secondary. The Isosporaserini were easier for the participants to find in this collection of tissue, but finding the flagellates, (Cochlosoma anatis) proved more difficult on the Hand E section (however, once the first flagellate were identified, participants were able to find them with ease.) Flagellates have a small, pinpoint nucleus and piriform shape, which differentiates them from mucin and debris. The group decided that there was not definitive evidence of cryptosporidia on the section of bursa, but only a very limited area of bursal epithelium (which cryptosporidia invade) was present in the section, so sampling was extremely limited.
This case provided a nice example of granulopoiesis in the liver, characterized by granulocytes that lacked a bilobed nucleus and clustered with hematopoietic precursors. It is easy to overlook or over-interpret extramedullary hematopoiesis, but knowing which species it is normally and commonly seen in is important. Birds, reptiles, and some rodents can routinely have foci of EMH in their livers. There was additionally some beautiful tertiary lymphoid follicle development in this case secondary to the chronic inflammation!
Evaluation of the bursa of Fabricius proved to be an important point of discussion. The bursa naturally involutes as birds age and should be a synchronous process.7 In chickens, the Bursa begins involution around 8-10 weeks of age and is generally heavily involuted by 6-7mo old.7 In this case, however, there was asynchronous depletion of the Bursa, indicating that this was not natural involution. There were some follicles that exhibited lytic central necrosis and lymphocytolysis, demonstrating an active insult to the Bursa that may have contributed to this bird?s immunosuppression. Whether this was viral or parasitic could not be determined. Although participants were not convinced about Cryptosporidium spp., the bursal epithelium are good places to hunt for them since the bursa of Fabricius is a continuation of the intestine. In trying to put a pathogenesis together in this case, participants thought that the most likely primary cause of this bird's demise was nutritional malabsorption due to the marked histiocytic enteritis with epithelial necrosis and crypt separation.
Finally, Dr. Pesavento quizzed participants on the ultrastructural images from this case, which was an appreciated, succinct review for many attendees. Key takeaways from this discussion included trusting your anchors (i.e. erythrocytes, nuclei, etc.), determining the number of cell profiles in the EM image, and knowing what normal looks like so you can evaluate the abnormal. The protozoal organisms on EM had some key characteristics to look for, as well, including the flagella on the Trichomonads with their classic microtubule 9+2 arrangement, and the apicomplexan conoid, rhoptries, and micronemes within the Isospora.5,6 Her last piece of wisdom in this case regarded microvilli on EM: don't call them microvilli unless you can see the actin microfilaments holding them up. If not, they are termed "cellular projections."
References:
- Ahearne MM, Pentzke-Lemus LL, Romano AM, Larsen ED, Watson AM, O'Fallon EA, Landolt GA. Disease progression, pathologic, and virologic findings of an equine influenza outbreak in rescue donkeys. J Vet Intern Med. 2022; 36(6):2230-2237.
- Boyle AG, Timoney JF, Newton JR, Hines MT, Waller AS, Buchanan BR. Streptococcus equi Infections in Horses: Guidelines for Treatment, Control, and Prevention of Strangles-Revised Consensus Statement. J Vet Intern Med. 2018;32(2):633-647.
- C?mara RJF, Bueno BL, Resende CF, Balasuriya UBR, Sakamoto SM, Reis JKPD. Viral Diseases that Affect Donkeys and Mules. Animals (Basel). 2020;25;10(12):2203.
- Carvallo FR, Stevenson VB. Interstitial pneumonia and diffuse alveolar damage in domestic animals. Vet Pathol. 2022;59(4):586-601.
- Carvallo FR, Uzal FA, Diab SS, Hill AE, Arthur RM. Retrospective study of fatal pneumonia in racehorses. J Vet Diagn Invest. 2017;29(4):450-456.
- Chambers TM. Equine Influenza. Cold Spring Harb Perspect Med. 2022; 4;12(1):a038331.
- Crawford PC, Dubovi EJ, Castleman WL, Stephenson I, Gibbs EP, Chen L, Smith C, Hill RC, Ferro P, Pompey J, Bright RA, Medina MJ, Johnson CM, Olsen CW, Cox NJ, Klimov AI, Katz JM, Donis RO. Transmission of equine influenza virus to dogs. Science. 2005; 21;310(5747):482-5.
- Dionisio L, Medeiros F, Pequito M, Faustino-Rocha AI. Equine influenza: a comprehensive review from etiology to treatment. Anim Health Res Rev. 2021; 22(1):56-71.
- Landolt GA. Equine influenza virus. Vet Clin North Am Equine Pract. 2014; 30(3):507-22.
- Rahman A, Uzal FA, Hassebroek AM, Carvallo FR. Retrospective study of pneumonia in non-racing horses in California. J Vet Diagn Invest. 2022; 34(4):587-593.
- Singh RK, Dhama K, Karthik K, Khandia R, Munjal A, Khurana SK, Chakraborty S, Malik YS, Virmani N, Singh R, Tripathi BN, Munir M, van der Kolk JH. A Comprehensive Review on Equine Influenza Virus: Etiology, Epidemiology, Pathobiology, Advances in Developing Diagnostics, Vaccines, and Control Strategies. Front Microbiol. 2018; 6(9):1941.
- Timoney PJ. Equine influenza. Comp Immunol Microbiol Infect Dis. 1996; 19(3):205-11.
- Yang H, Xiao Y, Meng F, Sun F, Chen M, Cheng Z, Chen Y, Liu S, Chen H.